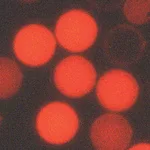
Thermo Fisher Scientific Fluoro-Max Fluorescent Carboxylate-Modified Particles with Europium Chelate, 0.1μm dia., Carboxylate-Modified

Thermo Fisher Scientific 1233110000000000
상품 한눈에 보기
Thermo Fisher Scientific의 고품질 연구용 시약 및 실험 기자재로, 안정적인 성능과 높은 재현성을 제공합니다. 생명과학 및 바이오 연구에 적합하며, Thermo Fisher의 신뢰성 있는 품질 관리 기준을 충족합니다.
✨AI 추천 연관 상품
AI가 분석한 이 상품과 연관된 추천 상품들을 확인해보세요
연관 상품을 찾고 있습니다...
Thermo Fisher Scientific 1233110000000000
제품 개요
Thermo Fisher Scientific에서 제공하는 고품질 연구용 시약 및 실험 기자재입니다. 생명과학, 분자생물학, 생화학 등 다양한 연구 분야에서 사용되며, 신뢰성 있는 결과를 제공합니다.
주요 특징
- Thermo Fisher Scientific의 정품 제품
- 높은 품질과 안정된 성능
- 다양한 실험 환경에서 재현성 있는 결과 제공
- 연구 효율성을 높이는 최적화된 구성
제품 스펙
| 항목 | 내용 |
|---|---|
| 브랜드 | Thermo Fisher Scientific |
| 제품 코드 | 1233110000000000 |
| 용도 | 생명과학 및 바이오 연구용 |
| 형태 | 시약 또는 실험 기자재 (상세 정보는 공급업체 확인 필요) |
| 공급업체 | Thermo Fisher Scientific |
제품 이미지
(이미지 정보 없음)
🏷️Thermo Fisher Scientific 상품 둘러보기
동일 브랜드의 다른 상품들을 확인해보세요

Thermo Fisher Scientific
Thermo Fisher Scientific Axiom Genotyping Services, Non-Human Custom 96
100원

Thermo Fisher Scientific
Thermo Fisher Scientific Axiom BloodGenomiX Reporter Software, 1 Report

Thermo Fisher Scientific
Thermo Fisher Scientific 1233110000000000

Thermo Fisher Scientific
Thermo Fisher Scientific 121123000000000
Thermo Fisher Scientific
Thermo Fisher Scientific Fluoro-Max Fluorescent Carboxylate-Modified Particles with Europium Chelate, 0.1μm dia., Carboxylate-Modified
배송/결제/교환/반품 안내
배송 정보
| 기본 배송비 |
| 교환/반품 배송비 |
|
|---|---|---|---|
| 착불 배송비 |
| ||
| 교환/반품 배송비 |
| ||
결제 및 환불 안내
| 결제수단 |
|
|---|---|
| 취소 |
|
| 반품 |
|
| 환급 |
|
교환 및 반품 접수
| 교환 및 반품 접수 기한 |
|
|---|---|
| 교환 및 반품 접수가 가능한 경우 |
|
| 교환 및 반품 접수가 불가능한 경우 |
|
교환 및 반품 신청
| 교환 절차 |
|
|---|---|
| 반품 절차 |
|
문의 0
로그인 후 문의를 할 수 있습니다.